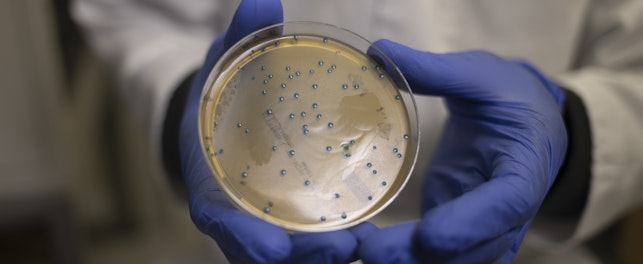
Scientist with Petri Dish

SGS, leader mondial des tests, de l'inspection et de la certification des cosmétiques, s’associe au laboratoire Ephyla, via son initiative EcoSeaStems, pour développer un test complémentaire en écotoxicologie sur les coraux. Véritable innovation, le test “ReefTox” vise à évaluer l’impact toxicologique d’un ingrédient cosmétique ou d’un produit cosmétique sur une population de coraux représentative des zones de baignades tropicales/indopacifiques (dite « triangle de corail »). Ainsi, contrairement à ce qui existe déjà sur le marché, ce nouveau test développé par Vincent Bourgeteau, biologiste au sein d’EcoSeaStems, évalue la toxicité des produits sur 50 espèces/spécimens de coraux durs et mous (ReefTox 50) afin d’obtenir une représentation réelle de la population corallienne. Une version sur 12 coraux (ReefTox12) est également proposée en cas de doute sur le produit ou la formule afin d’écarter le risque d’endommager un trop grand nombre de boutures.
« Depuis 1 an, les demandes de tests de nos clients s’orientent vers l’écotoxicité et la biodégradabilité de leurs produits permettant ainsi de vérifier l'effet d'un ingrédient ou d'un produit fini sur l'environnement. Tester l’impact des produits cosmétiques sur les coraux nous permet d’accompagner nos clients vers leur quête de naturalité. Ce nouveau partenariat s’inscrit dans notre démarche initiée depuis plus de 20 ans dans la réalisation des essais d’écotoxicologie (et de biodégradabilité) en eau de mer et en eau douce sur les matières premières ou formules cosmétiques et en particulier sur les produits solaires » souligne François RICHEUX COO Cosmetic et hygiène au sein du groupe SGS.
« Nous sommes fiers d’avoir réussi à développer ce test, inédit en France. Nous avons commencé à travailler sur le sujet en 2020 au début du confinement. Au niveau mondial, un grand nombre de laboratoires cosmétiques ont banni les filtres UV chimiques et sont passés aux filtres minéraux. ReefTox est une réponse optimale pour mesurer l'impact de ces reformulations sur les milieux coralliens » précise Vincent Bourgeteau, biologiste au sein d’EcoSeastemS.
Les Coraux essentiels dans l’écosystème
Les coraux qui s’assemblent pour former des récifs coralliens abritent 25% de la vie marine de notre planète soit près de deux millions d’espèces différentes qui vivent dans, sur et autour des récifs du monde. 500 millions de personnes vivent grâce aux coraux. Pourtant, on considère qu’environ un quart des récifs coralliens mondiaux a déjà subi des dégâts irréversibles, et que deux tiers sont gravement menacés. En cause, encore et toujours les activités humaines qui dégradent peu à peu les habitats marins.
Les fondements d’un test inédit
Afin d’évaluer l’impact d’un ingrédient cosmétique, à court et moyen termes, sur 50 espèces de coraux, les coraux sont répartis dans un aquarium d’eau de mer dont les paramètres physico-chimiques (température, pH, oxydo-réduction, salinité) sont contrôlés afin de répondre aux exigences de cultures des coraux. Après une période d’adaptation (2h), l’échantillon à tester est dosé puis mis en contact avec les coraux pendant approximativement 24h. Durant cette période, un suivi régulier des paramètres physico-chimiques de l’eau, de l’état général et de la survie des coraux est réalisé par et sous le contrôle d’un spécialiste de l’aquaculture de coraux.
A l’issue de la période de mise en contact, les coraux sont transférés dans des aquariums de quarantaine, contenant de l’eau de mer standardisée, pour une période de 2 semaines. Lors de cette période de quarantaine un suivi régulier de l’état général et de la survie des coraux ainsi que des paramètres physico-chimiques est assuré par un spécialiste de l’aquaculture des coraux.
L’évaluation de la survie et de l’état général des coraux, ainsi que des différents paramètres physico-chimiques pendant les périodes de mise en contact et de quarantaine permet de réaliser une évaluation à court et moyen termes de l’impact des produits à tester.
SGS, une offre globale pour le monde de la cosmétique en quête de naturalité
Doté d'une expertise reconnue dans le monde entier dans le secteur des tests de cosmétiques, d'audit et de certification, SGS France réalise chaque année plus de 15 000 tests et collabore avec plus 800 clients pour leur proposer une large gamme de services pour aider les marques à vérifier la sécurité, la qualité et la performance de leurs produits et les accompagner dans leur processus de transition écologique.
Cela passe par la vérification de la conformité des produits cosmétiques et de soins personnels avec les exigences de la réglementation applicable et d'autres réglementations pertinentes sur les cosmétiques, les aérosols et les substances dangereuses. Les experts SGS peuvent également vérifier la conformité des produits et procédés de fabrication aux diverses normes sociales et environnementales. En parallèle, dans le cadre de l’économie circulaire, les équipes de SGS sont plébiscitées sur des problématiques de vrac, de conditionnement réutilisable (recyclé ou non) pour des questions techniques, de dosage et de réglementation.
À propos de SGS
Nous sommes SGS, le leader mondial du testing, de l’inspection et de la certification. Nous sommes reconnus comme la référence mondiale en termes de durabilité, de qualité et d’intégrité. Nous employons plus de 97 000 collaborateurs et exploitons un réseau de plus de 2 650 bureaux et laboratoires à travers le monde qui travaillent pour permettre un monde meilleur, plus sûr et plus interconnecté.
À propos d’Ephyla
EPHYLA est un laboratoire français dédié au développement d’actifs issus de la Chimie Verte et de nouveaux concepts de formulations pour l’industrie cosmétique. Il est basé à Arzal dans le Morbihan et emploie 12 personnes. L’entreprise propose des solutions intégrées incluant des matières premières spécifiques, des actifs dont l’efficacité est prouvée, des processus d’extraction et de production innovants.
À propos d’EcoSeaStems
Avec ReefTox, EcoSeastems est le partenaire de SGS en tant que spécialiste des tests et évaluations ecotoxicologiques sur coraux.